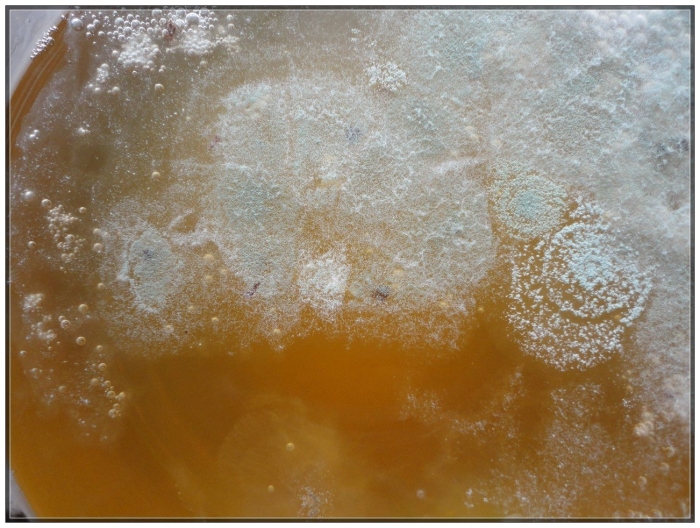
Плесень на комбуча
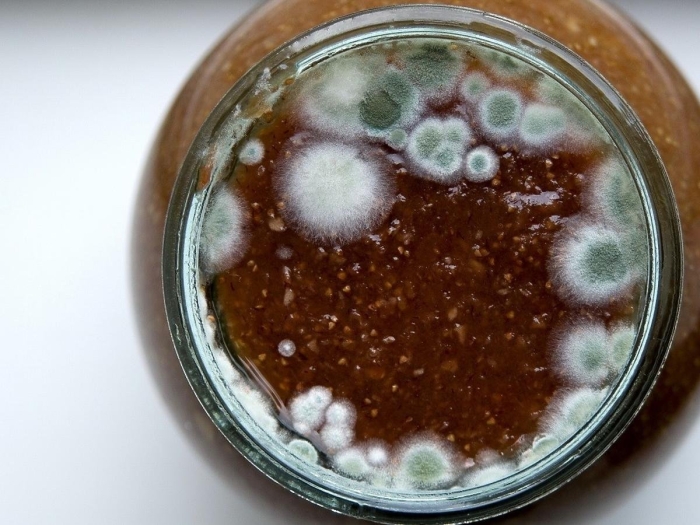
Плесень на варенье

Грибы покрылись белым налетом (64 фото)

Ежовик гребенчатый мицелий

Мучнистая роса налет

Плесень на хлебе

Говорушка беловатая ядовитый гриб

Гипомицес млечниковый

Цитоспороз смородины

Мучнистая роса

Powdery mildew

Белая плесень мукор

Ложная мучнистая роса

Penicillium chrysogenum

Вешенки плесень белая

Лишайник на коре дерева

Плесень на чайном грибе

Пятна на одежде после стирки

Белая плесень мукор

Мучнистые червецы

Мучнистая роса

Вешенка гриб устрица

Родотус дланевидный

Мучнистая роса смородины

Мучнистая роса – erysiphe cichoracearum

Гриб плесень

Густое масло для волос крапивное
Плесень на комбуча

Вёшенка обыкновенная

Шитаки гриб

Выращивание шампиньонов в домашних условиях

Накипные лишайники на деревьях

Нитчатые водоросли в морском аквариуме

Белая плесень

Плесень аспергилл черный

Белый мучнистый червец

Примордии вешенки

Белая гниль (склеротиния).

Водоросль каролина морской аквариум

Ложная мучнистая роса

Серая плесень

Плесень на хлебе

Плесневые грибы микоз

На коре яблони лишайник

Соленые грузди ботулизм

Замороженные грибы

Грибы вешенки 300 г

Белая гниль

Сажистый грибок на коре яблони

Мучнистая роса каннабис

Гипомицес млечниковый

Чайный гриб

Чайный гриб заплесневеть

Trichoderma harzianum мицелий

Домовый гриб serpula lacrymans

Склеротиниоз рапса
Плесень на варенье

Ложнодождевик гриб

Мучнистая роса на флоксах

Зарождение чайного гриба
Поделиться фото в социальных сетях:
Комментариев (0)
Похожие фото:











